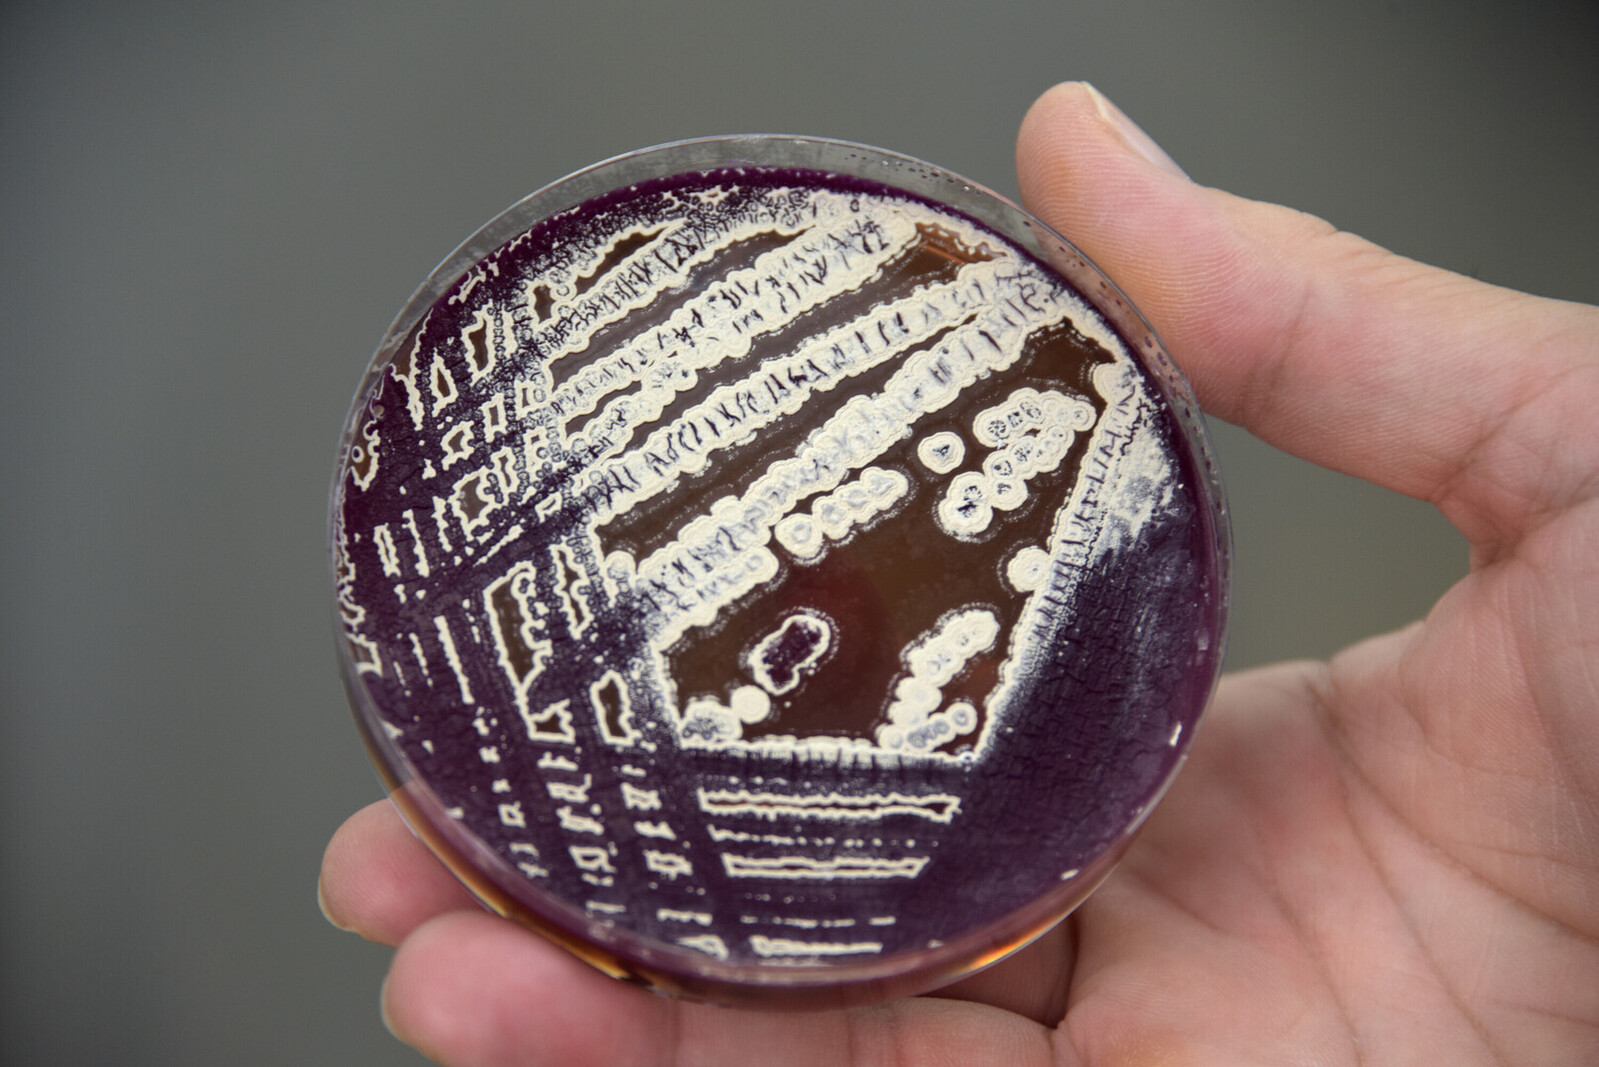

Dr. Molina: “Costa Rica está entre los países con los niveles más graves de bacterias resistentes”
Tal vez usted ya lo conozca. Su nombre es José Arturo Molina Mora, es microbiólogo y fue una de las principales voces durante la pandemia del COVID-19 que explicó por qué se generaban las mutaciones del SARS-CoV-2 y los escenarios que el país podría afrontar ante ese desafiante contexto.
En ese momento, el Dr. Molina dejó clara su habilidad para comprender, contextualizar y explicar temas genéticos altamente complejos en palabras sencillas. Ahora, sabemos que estos no son sus únicos talentos.
Desde la Maestría en Bioinformática, del Sistema de Estudios de Posgrado (SEP) de la Universidad de Costa Rica (UCR), el Dr. Molina se ha convertido en un nuevo referente científico para uno de los temas de mayor complejidad y urgencia mundial: el uso de la bioinformática para estudiar la resistencia a los antibióticos.
De acuerdo con la última Revisión de la Resistencia Antimicrobiana del Reino Unido, la resistencia de las bacterias está generando el fallecimiento de casi 700 000 personas cada año en el mundo y, si la situación no cambia, para el 2050 podría cobrar la vida de más de 10 000 millones en todo el orbe.
Esa proyección se respaldó aún más a finales del 2022 con el último informe emitido por la Organización Mundial de la Salud (OMS). Este informe reveló altos niveles de resistencia en bacterias causantes de septicemias (infecciones potencialmente mortales), así como una creciente resistencia de los patógenos bacterianos más comunes a varios de los tratamientos existentes.
En palabras más sencillas, el mundo se está quedando sin fármacos capaces de contrarrestar bacterias altamente dañinas para el ser humano, desde las más comunes hasta las más raras. Este es un hecho que el Dr. Tedros Adhanom Ghebreyesus, Director General de la OMS, “erosiona la medicina moderna y pone millones de vidas en peligro”.
“Las infecciones bacterianas comunes presentan cada vez mayor resistencia a los tratamientos. Más del 60 % de las cepas aisladas de Neisseria gonorrea, causante de una frecuente enfermedad de transmisión sexual, han mostrado resistencia a uno de los antibacterianos más utilizados por vía oral, la ciprofloxacina. Más del 20 % de las cepas aisladas de E. coli, que es el patógeno más común en las infecciones de las vías urinarias, resultaron resistentes tanto a los fármacos de primera línea (ampicilina y cotrimoxazol) como a los tratamientos de segunda línea (fluoroquinolonas)”, indica el comunicado de la OMS.
En ese campo Costa Rica no es la excepción. El Dr. Molina aseguró que Costa Rica está entre los países con los niveles más graves de bacterias resistentes, situación que se ha demostrado ya en diversidad de artículos científicos como el Infection & Chemotherapy. Este documento posiciona a Costa Rica como un país con alta resistencia a los carbapenémicos (los antibióticos más avanzados que existen hasta hoy para tratar infecciones severas).
Por eso, ante un tema de tan profundo entendimiento, con muchas aristas y misterios genéticos, el Dr. Molina decidió conversar en profundidad sobre la problemática, el panorama que vive Costa Rica y, por supuesto, el enorme esfuerzo que realiza el Sistema de Estudios de Posgrado (SEP) de la UCR para impulsar, a partir de sus diferentes posgrados, maestrías y doctorados, investigaciones que ayuden a transformar positivamente la salud de todo un país.
Entre ceros y unos
—Dr. Molina, tenemos muchos científicos en la UCR y en Costa Rica que ven el tema de la resistencia bacteriana a los antibióticos, pero usted lo hace un poco diferente y es desde la bioinformática. Incluso, la UCR es la única universidad del país que tiene una Maestría en Bioinformática en la cual usted es docente.
Entonces, antes de interiorizar este tema tan complejo, empecemos por lo más básico. ¿Qué es la bioinformática y por qué es tan relevante para el tema de la resistencia bacteriana?
—José Arturo Molina Mora (JAMM): "La bioinformática es el análisis masivo de datos moleculares para extraer información biológicamente relevante de los organismos vivos en poco tiempo. En el caso de las bacterias, la importancia radica en que nos permite tener más insumos para comprender por qué se está dando la resistencia a los antibióticos.
Históricamente, el tema de resistencia a los antibióticos posee muchas aristas y se puede abordar desde diversos ámbitos. Ya hay un trabajo que se hace desde los hospitales, en el cual a pacientes específicos se les realiza una evaluación para tratar de predecir cuál va a ser la efectividad del tratamiento antibiótico.
A esa prueba se le llama “Prueba de sensibilidad a los antibióticos”, es de rutina y lo que hace es probar una lista de antibióticos para determinar, en palabras muy sencillas, si la bacteria se muere o no se muere al aplicar ese medicamento.
¿Qué se ha visto hasta ahora? Nuevas versiones de esas bacterias que adquieren genes de resistencia y que podrían hacer fallar un tratamiento. Justamente, por eso a nivel de laboratorio clínico se hace esa valoración o prueba para que el personal médico pueda decidir cuál es la mejor opción terapéutica.
Ahora bien, el entender por qué se da esa resistencia es muy relevante y en esto la bioinformática es una aliada importante. Esta no solo ayuda desde el punto de vista de atención de un individuo, sino que también facilita la toma de decisiones a nivel de política pública. La bioinformática da la posibilidad de conocer la dinámica de comportamiento de la bacteria, por ejemplo, el origen de esa resistencia, y tomar acciones concretas y más efectivas.
Así, sabemos con mayor certeza si la resistencia que presenta una bacteria se debe a una mutación importada de otro país o si es un mecanismo nuevo que no había sido reportado jamás y se identificó por primera vez en Costa Rica. Esto lo podemos estudiar solo a través de la investigación y de los análisis bioinformáticos, para luego ligarlo a la problemática que viven los hospitales.
Nuestras investigaciones en bioinformática son una gran oportunidad científica para describir los mecanismos a los cuales obedece esa resistencia y, como te decía antes, con esto podemos brindar insumos para tomar decisiones en política pública, profundizar sobre las implicaciones de los medicamentos que adquiere el país y vigilar el escenario que hay a nivel regional y global para regular y recomendar el buen manejo y uso de los antibióticos. Mucho de este entendimiento sale de estos estudios”.
—De hecho, recuerdo que la bioinformática es un área que usted ya venía trabajando por varios años. Durante la pandemia del COVID-19 usted fue uno de los principales voceros que explicó por qué se daban las mutaciones del SARS-CoV-2.
—JAMM: "Sí. Como parte de mis estudios académicos, yo me especialicé a nivel de maestría y doctorado en esta área de la bioinformática. Llevo más de 10 años en este campo.
Por lo que vimos en la pandemia, la bioinformática resultó muy conveniente para todo lo que fue el análisis de vigilancia genómica del SARS-CoV-2, el cual sigue vigente. Pero, en realidad, esto fue algo muy particular de la pandemia. La bioinformática ya la veníamos trabajando desde el tema de bacterias, principalmente las resistentes.
Uno de los científicos que ha trabajado en este campo desde la parte conceptual y con diferentes estudios es el Dr. Fernando García. Yo empecé hace más de 10 años a trabajar con él y una de las aristas que hacía falta en este tipo de estudios era una parte especializada de análisis de datos (la bioinformática). Ese vacío me interesó mucho y vi que era una buena oportunidad de estudio que necesitaba el país”.
—Excelente, Dr. Molina. Hasta ahora queda claro que la bioinformática da ese valor agregado, de analizar de manera masiva datos biológicos, algo que no da otra disciplina.
—JAMM: "Precisamente. Si recordamos las clases de biología, entonces sabemos que conocer la existencia del ADN, ARN, las proteínas, los metabolitos y demás, ha permitido hacer avances grandísimos en los últimos 20 años en las ciencias médico-biológicas. Sin embargo, estos avances solo fueron posibles hasta cuando se aplicaron las estrategias de análisis masivo de datos. Aquí se potencia la bioinformática.
El análisis masivo de datos en poco tiempo, que nos da la bioinformática, surge en forma paralela al desarrollo de técnicas que permiten evaluar las moléculas de ADN y todos sus productos.
A partir de la Maestría de Bioinformática, hemos logrado desarrollar oportunidades para los estudiantes a nivel de posgrado y vincularlos con proyectos que tienen un impacto real, no solamente en la vigilancia de los patógenos en el país, sino en la salud de las y los costarricense a través de las valoraciones clínicas”.
La situación país
—Muy bien, Dr. Molina. Ahora quiero saber, desde su criterio, la situación que vive el país. El contexto internacional es claro: más de 10 000 millones de vidas podrían perderse, según la última Revisión de la Resistencia Antimicrobiana del Reino Unido.
Algo similar dijo la OMS a finales del 2022, cuando manifestó la existencia de elevados niveles de resistencia en bacterias causantes de septicemias potencialmente mortales. Pero, con los aportes realizados desde la Maestría en Bioinformática de la UCR, que tiene ya 10 años de impartirse en el país, ¿qué panorama han logrado ver en Costa Rica?
—JAMM: "La región de América Latina, incluido Costa Rica, está entre los países con los niveles más graves de bacterias resistentes a los antibióticos.
Me acuerdo perfectamente cuando empezaron a salir los primeros casos de resistencia a los carbapenémicos, uno de los fármacos que constituyen de las últimas (y mejores) opciones terapéuticas que hay hasta el momento para tratar infecciones realmente graves. Si el carbapenémico no le funciona a un paciente, es muy probable que ningún otro antibiótico le vaya a funcionar.
En ese momento que aparecen los primeros casos de resistencia, muchos se asustaron porque consideraron que ya habíamos llegado al mismo escenario de otros países que empezaron a reportar resistencias y que hacían el manejo del paciente muy complicado.
Actualmente, nuestra situación es grave y hay varios estudios, como el publicado en el 2015 por la revista Infection & Chemotherapy, en el cual se señala que la resistencia a los carbapenémicos en Costa Rica es crítica. En ese famoso estudio viene un mapa y sale Costa Rica con una de las tasas más altas; es decir, una resistencia mayor al 50 %.
Adicionalmente, desde los estudios que hemos realizado en la maestría, en el 2010 encontramos que la bacteria Pseudomonas aeruginosa quedó en la categoría de máximo riesgo hospitalario: la categoría ST111 y la categorizamos, oficialmente, en el 2014”.
—¿ST111?
—JAMM: “Uno puede categorizar las bacterias. Una forma es la que da la Organización Mundial de la Salud y la otra es por riesgo, con un perfil genómico. En esta última, tenemos categorías de alto riesgo y una de esas es un acrónimo que se llama ST111.
Cuando encontramos que la bacteria Pseudomonas aeruginosa se clasifica como ST111 nos quiere decir que es un clon de alto riesgo. ¿Qué significa esto en palabras sencillas? Que son bacterias muy pocas veces reportadas en el mundo, con un perfil de éxito y de multirresistencia muy alto para causar infecciones intrahospitalarias o nosocomiales. Entonces, es una bacteria sumamente peligrosa y la ST111 es la categoría de riesgo más alta. La caracterización ST111 nos dice que son bacterias que se van a mantener viviendo en el hospital y nada las va a matar.
Por lo tanto, cuando se hizo la secuenciación del genoma de la bacteria Pseudomonas aeruginosa, inmediatamente vimos un perfil de alerta máxima. Lo triste de esto es que en el 2010 era inusual, hoy es la norma. Actualmente, encontrar bacterias ST111 en Costa Rica no es raro”.
—El ST111 es más que una bacteria resistente, ¿es así?
—JAMM: “Correcto. Una cosa es decir que tenemos una bacteria resistente a los antibióticos y otra cuando se categoriza como ST111, porque estamos confirmando que es una resistencia de alto riesgo. Cuando en Costa Rica se ensambló el genoma de Pseudomonas aeruginosa AG1, vimos que en el mundo solo había otros ocho aislamientos de ese tipo reportados con genoma completo.
Esto no significa que Pseudomonas aeruginosa no estuvieran en muchos otros lugares, sino que en Latinoamérica se dio el primer caso oficialmente registrado con características de este tipo. En su momento ese fue un hallazgo preocupante por el peligro que implicaba que no pudiera responder a los carbapenémicos”.
—En nuestro caso, ¿por qué vivimos esa resistencia en Costa Rica? ¿El panorama de nuestro país se diferencia, de alguna forma, del contexto de otras naciones?
—JAMM: "Mucho se debe al uso de antibióticos de forma libre y excesiva. Y bueno, no solo nosotros estamos mal, los países desarrollados también.
¿Qué pasa con Latinoamérica y en Costa Rica? Que las regulaciones que existen en nuestros países son muy pobres. Por ejemplo, los antibióticos aquí se usan en granjas para que los pollos o los cerdos no se enfermen, o bien, en algunos cultivos. Ya hay estudios que evidencian la presencia de antibióticos en estos alimentos que también ingresan a nuestro organismo cuando los comemos.
Por otro lado, este escenario de resistencia en Latinoamérica y Costa Rica está muy asociado a las condiciones socioeconómicas de las regiones. Está más que evidenciado que cuando hay un antibiótico nuevo se abusa de ese medicamento. Ese abuso es el gran motor que genera los altos niveles de resistencia que hoy estamos viviendo.
A eso hay que añadirle nuestra propia dinámica de no terminar los tratamientos antibióticos, la automedicación y, en ocasiones, la mala práctica médica. Ese abuso provoca que estemos seleccionando a las bacterias más fuertes sin necesidad de haberlas atacado y se quedan ahí, sobreviviendo a los antibióticos. Hasta por una gripe algunas personas toman un antibiótico que, para un virus, no les hará absolutamente nada”.
—Con respecto a ese último punto, ¿cómo podríamos explicarle a las personas (en palabras sencillas) la manera en que el abuso de antibióticos incentiva la resistencia bacteriana?
—JAMM: "Imaginemos un mar lleno de bacterias. Todas las bacterias de ese mar se van a morir por el antibiótico, pero solo hay dos que no se mueren porque la persona no terminó su tratamiento. En ese tiempo, esas bacterias activan mecanismos de defensa hacia la sustancia y se muestran resistentes.
Estas bacterias luego van a proliferar, se multiplicarán y hasta harán un nuevo grupo resistente que se volverán las más frecuentes”.
—Hasta ahora, ¿cuáles consecuencias ha vivido el país a raíz de ese escenario de la resistencia antimicrobiana, Dr. Molina?
—JAMM: "Una es el aislamiento de pacientes. Cuando en cierto momento trabajé en el hospital, era muy usual que se aislaran a los pacientes infectados con clostridiales (con la bacteria Clostridium difficile, por decir una de este grupo, y que ocasiona fuertes cuadros de diarrea). Ahora, los pacientes que tienen este tipo de resistencia a los carbapenémicos también se aíslan. Esto implica hacer un cuarto de aislamiento para pacientes de este tipo.
Otra consecuencia fue la movilidad de individuos. Se empezó a ver, por ejemplo, que surgían casos en un hospital. A estos se les debía trasladar a otro para que se les realizara un procedimiento, y se vio que la bacteria se asociaba a los espacios de estancia o traslado donde estaban. Se buscó la bacteria en la ambulancia y se encontró en las paredes y en el suelo después de haber trasladado a un paciente. Esto genera una implicación muy importante para los centros de salud.
Nosotros, desde la Maestría de Bioinformática, al tratar de hacer estas descripciones de cómo se movilizan las bacterias, podemos colaborar con las decisiones clínicas relacionadas con la forma de actuar o de tomar medidas.
Si no tenemos un control bueno de la problemática, ni entendemos los mecanismos de cómo ocurre o se disemina la bacteria, vamos a tener personas que no van a poder sobrevivir a la infección. Es importante conocer qué circula y cómo circula para generar cuartos de aislados, uso de equipo, movilización del paciente y nuevas opciones terapéuticas”.
Un aspecto relevante es que Inciensa es el responsable oficial de la vigilancia genómica y de patógenos en el país. La UCR brinda apoyo y uno es mediante la Maestría en Bioinformática, del Sistema de Estudios de Posgrado (SEP).
Foto: Anel Kenjekeeva.Los estudios
—En la Maestría de Bioinformática, ¿han tenido algún enfoque prioritario en cuanto a las bacterias patógenas que investigan?
—JAMM: "Sí y esa prioridad se da con base en la clasificación que tiene la Organización Mundial de la Salud (OMS). Recordemos que un patógeno significa que un organismo puede producir una enfermedad, pero que pueda producir enfermedad no significa que se generará una pandemia o sea grave. Por eso la OMS hizo una clasificación de las bacterias resistentes a los antibióticos que sí se consideran un problema grave.
En el primer grupo de la clasificación de la OMS están las bacterias consideradas como las de categoría uno o prioritario, que son aquellas resistentes a un tipo de antibiótico conocido como carbapenémicos.
Los carbapenémicos son parte de las últimas líneas de tratamiento, lo más avanzado que hay. Entonces, si una persona tiene resistencia a este tipo de antibiótico, tendrá un escenario terapéutico muy complicado. Por ese motivo, los proyectos que nosotros hemos desarrollado desde la Maestría ya por más de 10 años están asociados a las bacterias del grupo prioritario de la OMS, precisamente, los resistentes a los carbapenémicos.
Mucho de nuestro trabajo ha estado centrado en esa bacteria que le comentaba, la Pseudomonas aeruginosa (causante de infecciones urinarias y óseas), el cual ya tenemos una trayectoria liderada por el Dr. Fernando García con un proyecto más macro y luego, de mi parte, con el procesamiento de datos desde la bioinformática”.
—Cuando realizan estas investigaciones, ¿existe algún elemento en específico, en cuanto a la genética de las bacterias, que ustedes se enfocan en identificar?
—JAMM: "Sí y es en el cúmulo de las mutaciones. Cuando un patógeno empieza a reproducirse y diseminarse, es normal que empiece a tener cambios en su material genético, algo que hablamos mucho en la pandemia del COVID-19 en cuanto al virus del SARS-CoV-2.
Hay cambios en los nucleótidos, o sea esas letras G, C, A, T que conforman el ADN de la bacteria, y eso puede otorgarle algunas veces un cambio fenotípico (de apariencia) o de su comportamiento. Algunos de estos cambios no tienen ningún efecto, pero quedan como una marca.
Entonces, imaginemos que tenemos una bacteria que tiene 10 cambios en relación con su versión inicial. Es posible que esos 10 cambios se mantengan y, en el camino, se le empiecen a sumar otras mutaciones.
Con esa información uno inicia una serie de modelos matemáticos para hacer estimaciones. Incluso, si ya esta bacteria fue analizada en otras latitudes, tenemos la zona geográfica y el año, podemos hacer un perfil de secuenciación, alguna caracterización de los nucleótidos y ver cuáles mutaciones o cambios hay.
Por poner un escenario, digamos que los primeros reportes de la bacteria son de Europa. Posteriormente, la bacteria empezó su movimiento mediante el flujo de personas. Esos patógenos luego llegan a América y empiezan a adquirir nuevas mutaciones, pero conservan las que ya tenían en Europa. Así que hay mucha información que se puede explotar.
Otro caso es saber si fue aislado de un hombre o de una mujer. Incluso, si viene de un ser humano, de un animal o del ambiente como tal. Con esto se pueden hacer otros tipos de estudios de la movilidad, no solo geográfica, sino entre tipos de organismos: humanos, animales y ambiente.
Así, si seguimos el ejemplo anterior, podemos saber si el patógeno que llegó a América se movilizó al sur y si generó nuevas mutaciones, ya sea por los animales o por el ambiente”.
—Una trayectoria que se puede seguir muy bien mediante la bioinformática.
—JAMM: “Totalmente. Pero los patógenos no se mueven de forma lineal. Puede ser que de un lado se diseminó hacia el sur y por otro vuelve a Europa, luego Asia y por último se regrese a América. Hay un perfil de mutaciones que nos permite dar ese seguimiento.
La idea es describir todos los posibles escenarios y esa es la gran complejidad, porque el foco se puede diseminar hacia muchos lados. Los modelos matemáticos de la bioinformática ayudan a hacer estas inferencias”.
—¿Esos hallazgos que usted me menciona han sido mediante algún tipo de vínculo?
—JAMM: "Nosotros siempre tratamos de vincular el área de la bioinformática con los ámbitos sustanciales de la UCR: docencia, investigación y acción social. Hacemos formación, sí, pero también, desde el eje de acción social, tenemos un proyecto en el cual realizamos análisis de datos especializados, incluido el de la secuenciación de patógenos.
Con ese proyecto recibimos aislamientos que provienen de centros de salud para efectuar análisis especializados. Dichos análisis, a su vez, hacen que hoy tengamos una colección de patógenos de bacterias que logramos analizar aún más con el apoyo de la Vicerrectoría de Investigación. Aquí, por supuesto, también están los estudiantes de la Maestría en Bioinformática haciendo sus aportes.
Existen varios patógenos que se estudian en otros grupos de investigación, como las bacterias clostridios, y otros de interés veterinario: brucelas, virus e, inclusive gusanos, los llamados helmintos. Nuevamente, aclaro que las investigaciones sobre resistencia a los antibióticos no son exclusivas de nuestro grupo de la maestría, sino que hay varios grupos de investigación en la universidad y, en particular, muchos de ellos son de la Facultad de Microbiología”.
Muchas mentes
—Dr. Molina, además de las personas que conforman la Maestría en Bioinformática, ¿tienen conexiones con otras áreas académicas?
—JAMM: "Por supuesto. La maestría en bioinformática se dedica mucho al análisis de datos, pero hay una parte de laboratorio que no es tan común hacerla en la Maestría de Bioinformática o de la carrera de Licenciatura. Por lo tanto, nos vinculamos con otros posgrados como el de Microbiología.
A lo largo de estos años, en estos programas hemos generado unas 10 tesis asociadas al tema de la resistencia. La cifra depende mucho de la forma en cómo se formulen los proyectos. Normalmente, estos proyectos asociados a la bioinformática tienen un componente experimental orientado a obtener los aislamientos de las bacterias que, en el hospital, se dieron cuenta que tenían un perfil particular de resistencia.
Con el proyecto de acción social que le comentaba, recibimos el aislamiento y los estudiantes, incluidos los estudiantes de grado, generan un proyecto que puede tener varios objetivos. El primer paso siempre está en caracterizar el aislamiento a fin de conocer el tipo de bacteria resistente. A esto le llamamos pruebas fenotípicas, que a nivel de laboratorio nos dice cuáles son las características del organismo.
Ahí tenemos estudiantes de laboratorio, microbiología, biotecnología y biología dependiendo de donde se desarrolle la tesis.
Luego, tenemos la secuenciación, que son análisis más especializados, que al final nos permitirá aplicar, desarrollar u optimizar técnicas para apoyar el diagnóstico y la vigilancia genómica. Algo importante es que nosotros, al igual que otros grupos de investigación del mundo, hacemos mucho análisis de bases de datos”.
—¿A qué se refiere con “análisis de bases de datos”?
—JAMM: "Con revisar si han habido o no reportes de la bacteria y su mutación. Esto tiene un poder enorme porque pone en contexto, regional o mundial, lo que está sucediendo en una bacteria de un hospital de Costa Rica, por ejemplo.
Muchas veces nos hemos dado cuenta que un fenómeno se está reportando por primera vez o ya se ha reportado con algunas características. Asimismo, nos hemos dado cuenta de que la mutación de esa bacteria resistente se generó por primera vez en Costa Rica o, al menos, la primera vez que se reporta en Latinoamérica.
Por lo tanto, también aportamos mucho con el estudio de esa dinámica mundial y en hacer reconstrucciones de las posibles rutas de cómo se disemina un organismo”.
—Básicamente, saber cómo se movió de un país a otro, si fuese el caso.
—JAMM: "Exacto. Podemos ver cómo se movió el organismo, aunque puede ser complejo también. Por ejemplo, si primero estuvo en Norteamérica, empezó a bajar a Centroamérica y terminó en Sudamérica, por decir algo. Esa vigilancia nos ayuda a predecir futuros movimientos, el comportamiento y las condiciones especiales que requiere la bacteria antes de que se genere una gran movilidad, como lo hemos tenido en las últimas décadas".
Dr. Molina:
“En la práctica hospitalaria, la secuenciación es necesaria para saber qué mecanismos utiliza la bacteria para ser resistente. Aquí es donde aporta la UCR”.
La expectativa
—¿Cuál es el siguiente paso para ustedes, Dr. Molina? ¿En qué van a estar trabajando?
—JAMM: “Por ahora tenemos un proyecto nuevo que ya veníamos trabajando desde hace un tiempo, pero que ahora, finalmente, está formalizado. En este colabora la Caja Costarricense de Seguro Social y el Instituto Costarricense de Investigación y Enseñanza en Nutrición y Salud (Inciensa).
Este proyecto se llama: “iPAT: Plataforma genómica, bioinformática y de inteligencia artificial para la vigilancia de patógenos” y como parte de esta iniciativa tenemos una colaboración internacional con el Instituto Europeo de Bioinformática, que es parte de los máximos institutos de bioinformática del mundo. De hecho, el próximo mes voy a ir a dar una charla.
En esta colaboración nos enfocamos en todo el grupo considerado como prioridad uno por la Organización Mundial de la Salud, que son las Pseudomonas aeruginosa, Acinetobacter baumannii y las enterobacterias, todas ellas resistentes a los carbapenémicos. Nuevamente, porque esa es la prioridad en el mundo y desde la UCR vamos en línea para trabajar esto.
La idea en un futuro es trabajar este tema de la mano con el personal interdisciplinario de Trabajo Social, Enfermería y demás, porque muchos de los mecanismos, o cómo es que las bacterias se van pasando entre estos pacientes, están completamente vinculados. Imaginemos a una persona que anda repartiendo la comida, entró a un salón y se llevó la bacteria para otro lado. Por lo tanto, saber ese recorrido facilita la educación y el manejo de los pacientes que, si bien no es algo científico como tal, aporta en el día a día de un hospital.
Hablo mucho del hospital porque es donde hay una mayor relevancia, en el sentido de que ahí están los pacientes que están cursando una enfermedad. Una bacteria resistente dentro del centro médico podría generar un escenario complicado que lleve a la persona a estar hospitalizada por infecciones graves. Esas bacterias pueden estar en todas partes, en los pisos, en las paredes, en los dispositivos y en las comidas. Nuevamente, por eso es tan importante vigilar y hacer investigación”.
—Lo que usted me comenta es como en el caso de la bacteria Clostridium difficile, que ocasionó un brote en el Hospital San Juan de Dios en el 2009.
—JAMM: “Sí. Es un problema, no solamente de nuestro país, sino a nivel mundial. Incluso, en los países desarrollados. También existen otros escenarios, como los de infección adquirida en la comunidad.
Ahí el perfil es un poco diferente. Si las personas tienen un sistema inmune funcional, o no tan comprometido, en teoría se pueden resolver mucho mejor las infecciones. Lo grave son las personas que no tienen una buena salud. Entonces, son escenarios de escenarios. Las consecuencias de la resistencia a los antibióticos generan panoramas muy diversos que varían mucho de las condiciones”.
-—¿Y qué otras metas tienen en mente?
—JAMM: “Con el Instituto Europeo de Bioinformática queremos unir esfuerzos para crear una Red Latinoamericana de Bioinformática para el apoyo de la vigilancia de patógenos. Estas ideas que nosotros desarrollamos están muy asociadas con el contexto del SARS-CoV-2. De ahí fue donde vino el vínculo más fuerte.
Cuando yo estaba trabajando el tema del SARS-CoV-2 en Costa Rica, que nos fue muy bien, varios científicos de Latinoamérica se comunicaron conmigo y, como este proyecto del COVID-19 era parte de un proyecto más grande llamado “Cabana”, actualmente liderado por la Dra. Rebeca Campos del Centro de Investigación en Biología Celular y Molecular (CICBM-UCR) y financiado justamente por este Instituto Europeo de Bioinformática (IEB), logramos hacer la conexión.
Ahí tengo una publicación que fue sumamente compleja de 33 autores y la que dio paso a esta nueva iniciativa de unir esfuerzos de muchos países para hacer la vigilancia del SARS-CoV-2 en Latinoamérica para ahondar la resistencia a antibióticos. Esta es la iniciativa que tenemos actualmente. El “iPAT” es para Costa Rica, pero la idea es hacer una versión grande para Latinoamérica que es la que estamos construyendo.
Lo otro que tenemos es la llegada de una delegación China, el Instituto de Fenómica Humana. Durante mi doctorado pude estar en China. Por eso ahora tenemos un cierto vínculo UCR con otros ocho colegas más de la Universidad de Fudan, en Shanghai. Ellos vienen a Costa Rica con el interés de apoyar proyectos, algunos de los cuales soy el encargado, y con la idea de generar nuevos con más investigadores. El objetivo es tratar de hacer alguna iniciativa de colaboración entre las universidades para apoyar esta área de la bioinformática.
El objetivo incluye un plan para tratar de movilizar estudiantes hacia las dos direcciones. Además, la Universidad de Fundan desea financiar la creación de sus institutos en Latinoamérica. Justamente, los dos candidatos somos Costa Rica y Chile. También tenemos conexiones con España, Perú y Colombia”.
—Y bueno, si bien hemos venido hablando del tema de la resistencia de las bacterias a los antibióticos, sé que la bioinformática puede dar otros aportes.
—JAMM: “Sí. Hemos hablado de resistencia a los antibióticos porque hay un interés particular y es la principal línea de investigación que desarrollamos de nuestro grupo y en el contexto de la maestría, pero en el área de la bioinformática tenemos otros tipos de temas biológicos que exploramos mucho con estudiantes de tesis y, en particular, del posgrado.
Muchos de ellos están relacionados con cáncer. Incluso, tenemos más estudiantes en el tema del cáncer que en el área de la resistencia antimicrobiana. Aquí tenemos muchos grupos trabajando este tema, cuyos tutores son especialistas en el área”.

Periodista Oficina de Comunicación Institucional
Área de cobertura: ciencias de la salud
jenniffer.jiveivmenezcordoba @ucrtqhn.ac.cr
Comentarios:
Artículos Similares:
-
 "Costa Rica aprende con la U Pública" cumple tres años de vinculación de las universidades públicas …
"Costa Rica aprende con la U Pública" cumple tres años de vinculación de las universidades públicas … -
 Costa Rica recibirá a uno de los expertos internacionales más respetados en el estudio del cáncer
Costa Rica recibirá a uno de los expertos internacionales más respetados en el estudio del cáncer -
Una nueva unidad de la UCR abre sus puertas para que Costa Rica tenga medicamentos más baratos
-
 Voz experta: Costa Rica cuenta con una enorme riqueza en diversidad natural alimentaria que merece …
Voz experta: Costa Rica cuenta con una enorme riqueza en diversidad natural alimentaria que merece …
